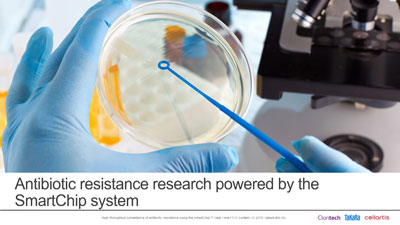
TakaraBioUSA's tweet image. Learn about the inspiring journey of @WMuziasari, CEO of @resistomap and how her company is helping fight the spread of antibiotic resistance genes by providing robust tools for monitoring: ow.ly/FxNN50AvpfD
#qPCR #realtimePCR #AntibioticResistance #COVID19 #TakaraBio

#realtimepcr search results
Perfect dissociation curves for selected primers. #qPCR #realtimePCR #curve #experiments #design #Reproductive_Biotechnology_KSU




#SobatHalalMUI, real-time PCR memiliki 3 tahapan utama, yaitu ekstraksi DNA, pembacaan konsentrasi dan kemurnian DNA serta amplifikasi DNA pd mesin real-time PCR, halalmui.org/mui14/main/det… . #realtimepcr #lab #labhalal #lph #lppommui #halalmui #halalindonesia #kamuharustau

🔬Instytut #ŁukasiewiczPORT posiada specjalistyczny sprzęt i wykorzystuje jedną najbardziej sprawdzonych technologii #RealTimePCR do badań w kierunku #koronawirus.a. Dzięki reakcji R-T PCR wykrywamy charakterystyczne dla #SARSCoV2 fragmenty RNA, czyli materiał genetyczny #wirus.a

#Inauguration of joint #training programme on "Application of #RealTimePCR" at @gbrc_gujarat. GBRC welcomes all participants to the training course. @ChaitanyaGJoshi @gsbtm @dstGujarat @hareets @subhashrsoni @KamdhenuU


🔬 Hands-on Training Workshop on the Real-Time PCR Machine (Signway 9600 Pro) was organized at BUITEMS today. 🎓 It was a successful event focused on diagnostics and research purposes. Thank you to all who participated! #PCRworkshop #BUITEMS #RealTimePCR #Diagnostics #research




Last week opened our new CFX Opus 96 @BioRadLifeSci and installed it at @fbioyfunr @IBR_CONICET @UNRoficial. Thanks to our funding source @FillingV 🙌 We are so exited to get started!! #qPCR #ThermalShift #RealTimePCR @Juli_Cricco @vikyalonso85 @ArayaElvio




Screenshot taken from @ChughtaiLab website, they claim to have #RealtimePCR test kits. How is it possible that these kits are available to only one private lab in #Lahore #Pakistan by @pid_gov @zfrmrza and @NIH_Pakistan @DCLahore @PakPMO @UsmanAKBuzdar @SHABAZGIL @iSupportPTI

Airport COVID test with high sensitivity real-time PCR Jersey. buff.ly/35nu14H #covid #realtimepcr #covidtest #lab #airport
Are you new to qPCR? Want to learn the basics of how it works, what to do and what not to do? Read our super popular "Beginners Guide to qPCR" - download the PDF here: ow.ly/WLqK50udknZ #qpcr #realtimepcr #phdchat #PhDForum #postdoc #phdlife

Learn about the inspiring journey of @WMuziasari, CEO of @resistomap and how her company is helping fight the spread of antibiotic resistance genes by providing robust tools for monitoring: ow.ly/FxNN50AvpfD #qPCR #realtimePCR #AntibioticResistance #COVID19 #TakaraBio

Tired of banging your tip against the tray? Then try #LinkSeq #RealTimePCR. No gels, no hassle! go.1lambda.com/2qTGHvC

Have you seen our range of qPCR video tips? Want to learn more about qPCR? Learn some top tips? Find out more here ow.ly/XQDU50wHG9j #qPCR #realtimePCR #qPCRtips #PhDchat #phdforum

We really value feedback from our customers about the products and services we provide; take a look at some of our feedback! primerdesign.co.uk/about/what-our… Click here to leave feedback, we'd love to hear from you: ow.ly/Xitd50wICvU #qPCR #Primerdesign #realtimePCR #research

Introducing the genesig q32 Real-Time PCR Instrument - Providing Fast Results with 550+ genesig qPCR Kits. With its rapid heating & cooling it's one the fastest qPCR instruments on the market today. Learn more & book a demo today! ow.ly/94pd50uRwGb #qPCR #realtimepcr #q32

📣Instytut #ŁukasiewiczPORT uruchomił Punkt Pobrań Drive-Thru🚘, w którym szybko i bezpiecznie można poddać się badaniu na obecność #koronawirus.a 💪. Testy wykonujemy metodą #RealTimePCR. Badanie trwa 1️⃣5️⃣ minut, a wyniki są już po 2️⃣4️⃣h. Więcej👉 bit.ly/3fMn3Ki

#HLA is complicated but your analysis software shouldn’t be. SureTyper software and LinkSeq #RealTimePCR… your lab techs will love you. go.1lambda.com/2HVhqcR

EziLab Real-Time PCR EZL-RTP100 is a (polymerase chain reaction) instrument suited for workflows such as gene expression analysis. Email: [email protected] Learn More: ezilab.com/real-time-pcr/… Hashtags: #EziLab #RealTimePCR #LaboratoryDiagnostics #LabEquipment #labInstruments

This pilot study evaluated MAT #Seropositivity and #RealTimePCR reactivity in Chilean #cattle, finding 39.3% MAT and 29.5% PCR positivity, with 75% overlap, and demonstrating that combined use enhances #leptospirosis diagnostic accuracy and #epidemiological insights.…

That feeling when your qPCR run goes perfectly and the data makes sense before noon on a Friday. 🙌 What's making your lab day awesome? For reliable data every time: bit.ly/4435gJj #qPCR #RealTimePCR #LabWins #ScienceMotivation #HappyFriday (or #WednesdayVibes if…
BR BIOCHEM'S BRAND REAL TIME PCR MACHINE Sample Capacity: 32x0.2ml Clear 0.2 ml PCR tube /8-tube Strip MAIL:[email protected] 📞 : +91 9910556131 #REALTIMEPCR

🥛 Not all milk is the same! A1 & A2 β-casein impact digestion differently. Anatolia’s Bosphore A1-A2 Genotyping Kit v1 detects both variants with high accuracy — even in processed dairy. Fast, reliable Real-Time PCR. Now available via Anatech! 🔬 #A2Milk #Anatech #RealTimePCR

🧬 Accurate diagnostics = better protection, early intervention, and peace of mind. 📩 Reach out to us today: thegenes4life.com #MolecularDiagnostics #RealTimePCR #GenesForLife #pcr #LabTechnology #Diagnostics

Precision meets performance in Real-Time PCR. Introducing GL-CQ41 & GL-CQ42 – compact, powerful, and ideal for veterinary, human, food, and water diagnostics. qtaqdx.com | 📩 [email protected] #RealTimePCR #MolecularDiagnostics #PCRTechnology #qPCR

Development of a Molecular Detection System for Argemone spp. - #Argemone #bioinformatics #realtimePCR #moleculardetection - link.springer.com/article/10.310…
Perfect dissociation curves for selected primers. #qPCR #realtimePCR #curve #experiments #design #Reproductive_Biotechnology_KSU




#SobatHalalMUI, real-time PCR memiliki 3 tahapan utama, yaitu ekstraksi DNA, pembacaan konsentrasi dan kemurnian DNA serta amplifikasi DNA pd mesin real-time PCR, halalmui.org/mui14/main/det… . #realtimepcr #lab #labhalal #lph #lppommui #halalmui #halalindonesia #kamuharustau

#Inauguration of joint #training programme on "Application of #RealTimePCR" at @gbrc_gujarat. GBRC welcomes all participants to the training course. @ChaitanyaGJoshi @gsbtm @dstGujarat @hareets @subhashrsoni @KamdhenuU


Learn about the inspiring journey of @WMuziasari, CEO of @resistomap and how her company is helping fight the spread of antibiotic resistance genes by providing robust tools for monitoring: ow.ly/FxNN50AvpfD #qPCR #realtimePCR #AntibioticResistance #COVID19 #TakaraBio
🔬Instytut #ŁukasiewiczPORT posiada specjalistyczny sprzęt i wykorzystuje jedną najbardziej sprawdzonych technologii #RealTimePCR do badań w kierunku #koronawirus.a. Dzięki reakcji R-T PCR wykrywamy charakterystyczne dla #SARSCoV2 fragmenty RNA, czyli materiał genetyczny #wirus.a

Congratulations to Hannah Morgan and her team from @UniofNottingham on winning our Amazon Echo Prize Draw! We hope you enjoy the new addition to your lab! #qPCR #realtimePCR #Primerdesign #UoNresearch

Have you seen our latest product promos? Benefit from big savings with the “genesig Kits and qPCR Master Mix Combo Promos”! Up to 40% discount - Learn more at: bit.ly/2wD55Dl #qPCR #realtimePCR

Introducing the genesig q32 Real-Time PCR Instrument - Providing Fast Results with 550+ genesig qPCR Kits. With its rapid heating & cooling it's one the fastest qPCR instruments on the market today. Learn more & book a demo today! ow.ly/pfdZ50uRwGa #qPCR #realtimepcr #q32

Last week opened our new CFX Opus 96 @BioRadLifeSci and installed it at @fbioyfunr @IBR_CONICET @UNRoficial. Thanks to our funding source @FillingV 🙌 We are so exited to get started!! #qPCR #ThermalShift #RealTimePCR @Juli_Cricco @vikyalonso85 @ArayaElvio




Are you new to qPCR? Heading to University? Learn how qPCR works, what to do and what not to do with our super popular "Beginners Guide to qPCR" - Download the PDF here! - ow.ly/yKU950udknV #qPCR #RealtimePCR #PhDChat #PhDForum #PostDoc #PhDLife #Biotechnology #Research

Are you new to qPCR? Want to learn the basics of how it works, what to do and what not to do? Read our super popular "Beginners Guide to qPCR" - download the PDF here: ow.ly/WLqK50udknZ #qpcr #realtimepcr #phdchat #PhDForum #postdoc #phdlife

Tired of banging your tip against the tray? Then try #LinkSeq #RealTimePCR. No gels, no hassle! go.1lambda.com/2qTGHvC

Have you seen our range of qPCR video tips? Want to learn more about qPCR? Learn some top tips? Find out more here ow.ly/XQDU50wHG9j #qPCR #realtimePCR #qPCRtips #PhDchat #phdforum

🔬 Hands-on Training Workshop on the Real-Time PCR Machine (Signway 9600 Pro) was organized at BUITEMS today. 🎓 It was a successful event focused on diagnostics and research purposes. Thank you to all who participated! #PCRworkshop #BUITEMS #RealTimePCR #Diagnostics #research




We really value feedback from our customers about the products and services we provide; take a look at some of our feedback! primerdesign.co.uk/about/what-our… Click here to leave feedback, we'd love to hear from you: ow.ly/Xitd50wICvU #qPCR #Primerdesign #realtimePCR #research

🔊 Bioline qPCR Ekstraksiyon Kontrolleri; ✨• Tek bir kontrolle ekstraksiyonu ve inhibitörlerin temizlenmesini birlikte takip edin. 🤩 ✅ • Özellikle multipleks qPCR testleri için tasarlanmış ve probe tabanlıdır. #Bioline #RealTimePCR #Meridian #DNA #qPCR #RTPCR #covid19

Want to learn more about Thermo Fisher's QuantStudio DX Real-Time PCR system? Download free resource guides here: bit.ly/3GuTo5r #realtimePCR #qPCR #LabEquipment #ad

Something went wrong.
Something went wrong.
United States Trends
- 1. #StrangerThings5 63.8K posts
- 2. Thanksgiving 566K posts
- 3. Afghan 170K posts
- 4. #AEWDynamite 18K posts
- 5. National Guard 518K posts
- 6. #Survivor49 2,379 posts
- 7. holly 27.3K posts
- 8. Kevin Knight 2,159 posts
- 9. Rahmanullah Lakanwal 69.4K posts
- 10. dustin 82.5K posts
- 11. Cease 27.6K posts
- 12. Doris Burke N/A
- 13. robin 48.2K posts
- 14. Chet 4,408 posts
- 15. Rizo 2,107 posts
- 16. #SistasOnBET 1,208 posts
- 17. Celtics 14.2K posts
- 18. Blood 256K posts
- 19. Gobert 1,618 posts
- 20. Operation Allies Welcome 23K posts

































